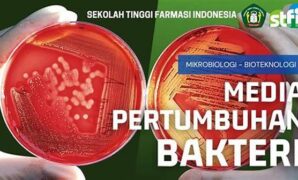
pengaruh-media-kental-pada-bakteri_42e1f3378.jpg

Perkembangan bioteknologi modern telah membawa perubahan signifikan dalam dunia kesehatan. Seiring dengan kemajuan teknologi, bioteknologi semakin memainkan peran penting dalam […]
Month: October 2025
Sistem Enzimatis Untuk Produksi Biodiesel
Produksi biodiesel secara konvensional telah mengalami banyak perubahan seiring perkembangan teknologi terbaru. Salah satu metode yang semakin mendapat perhatian adalah […]
Pengaruh Media Kental Pada Bakteri
Media pertumbuhan bakteri sangat penting untuk mendukung penelitian dan aplikasi bioteknologi. Media kental, salah satu jenis media, memiliki peran unik […]
Suhu Ideal Untuk Fermentasi Enzim
Fermentasi enzim adalah salah satu proses penting yang digunakan dalam berbagai industri, mulai dari makanan hingga farmasi. Dalam proses ini, […]
“manfaat Sel Punca Bagi Kesehatan”
Dalam beberapa tahun terakhir, sel punca telah menjadi topik diskusi hangat di dunia medis. Sel ini menyimpan potensi besar bagi […]
Efikasi Terapi Biosintetik Insulin
Di era modern ini, diabetes menjadi salah satu penyakit kronis yang memiliki prevalensi tinggi di seluruh dunia. Salah satu aspek […]
Kontribusi Ilmuwan Di Bidang Bioteknologi
Perkembangan teknologi di era modern ini tidak terlepas dari peran penting para ilmuwan yang terus berinovasi dan memberikan kontribusi berharga. […]
Keamanan Vaksin Nano Untuk Manusia
Seiring dengan perkembangan teknologi medis, vaksin nano telah menjadi topik hangat dalam dunia kesehatan. Vaksin nano menawarkan janji untuk meningkatkan […]
Penerapan Nanopartikel Dalam Terapi Obat
Inovasi dalam dunia farmasi terus berkembang seiring dengan kemajuan teknologi. Salah satu perkembangan mutakhir yang menjanjikan adalah penerapan nanopartikel dalam […]
Pengaruh Polusi Terhadap Kulit Wajah
Kulit wajah adalah salah satu area tubuh yang sering terpapar dengan berbagai elemen dari lingkungan sekitar kita. Mulai dari sinar […]